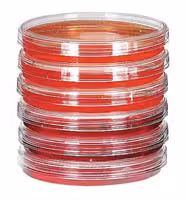
Boîte de Pétri stérile x 500

Gauss
Pipette 25 ml stérile 20 / sachet x 200
Réf.
UGAP : 2582550
Réf.
Fournisseur : 86.1685020
Réf.
Constructeur : 861685020
Franco de port et d'emballage pour toutes les commandes supérieures à 80€ HT.
Description
Caractéristiques
- Traitement de surface
- irradiation
- Présence d'une graduation
- oui
- Présence de coton
- oui
- Matière
- PS
- Longueur
- 345 mm
- Coloris
- rouge
- Volume
- 25 ml
- Nomenclature CNRS
- NB04
- Conditionnement
- sachet de 20
- Marque
- SARSTEDT
- Classement dans le catalogue fournisseur
- PIPETTE PLASTIQUE GRADUEE
- Type de produit
- pipette
- Fournisseur
- SARSTEDT
- Quantité
- 200
- Référence distributeur
- 86.1685020
- Téléphone du titulaire
- 03.84.31.95.407
- Usage recommandé
- manipulation des liquides
- Dispositif stérile
- oui
- Usage unique
- oui
- Lieu de stockage
- Allemagne
- Lieu de fabrication
- France
- Nomenclature CEA
- SHP16
- Libellé produit fabricant
- Pipette 25 ml, stérile, 20 / sachet
- Libellé produit habituel
- Pipette 25 ml, stérile, 20 / sachet
- Référence fabricant
- 86.1685020
- Reprise en cas d’erreur client
- oui
- Nomenclature CHU
- 18.51.
- Nomenclature IFPEN
- NB.04
- Nomenclature Nacres
- NB.04
- Nomenclature IRSN
- 189
- Nomenclature INSERM
- NB.NB04